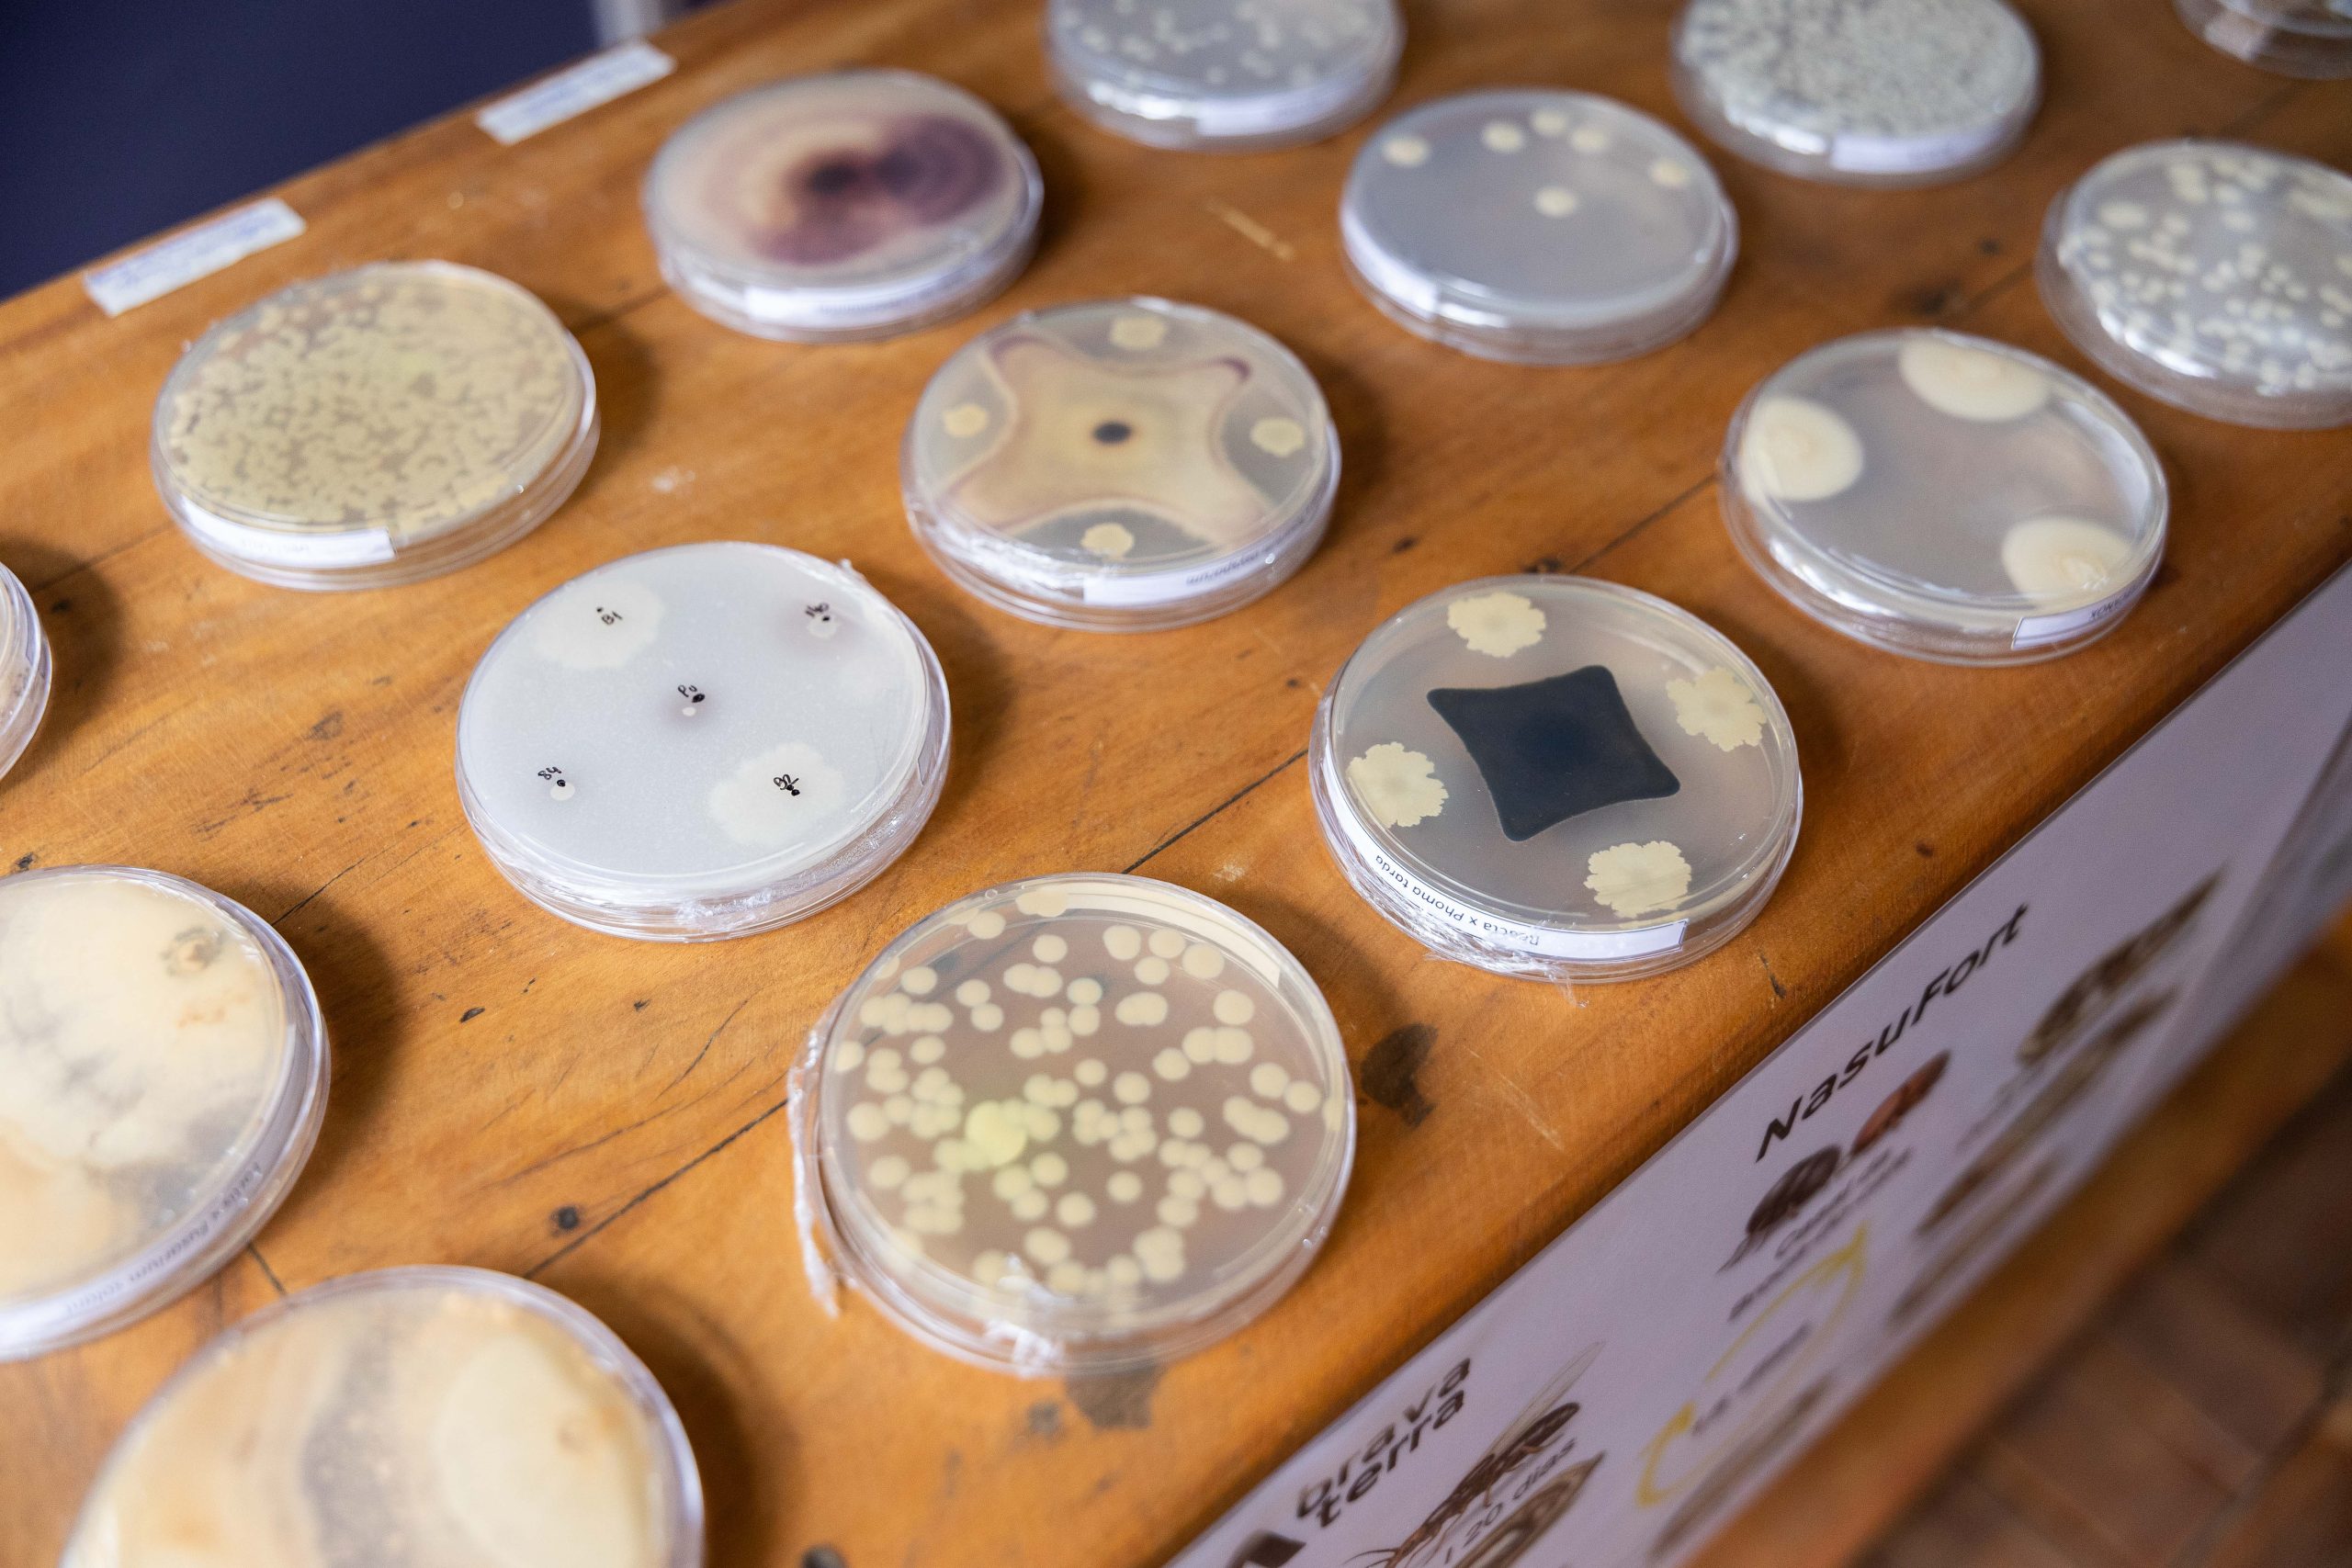

Notícias.

Alta Café 2026 encerra edição reforçando conexões, inovação e potencial de negócios no setor cafeeiro

Rota do Café aproxima visitantes da origem e reforça conexão entre produção e experiência na Alta Mogiana
Inovações apresentadas na 6ª Alta Café incentivam produtores a repensarem práticas no campo
Patrocinador master















